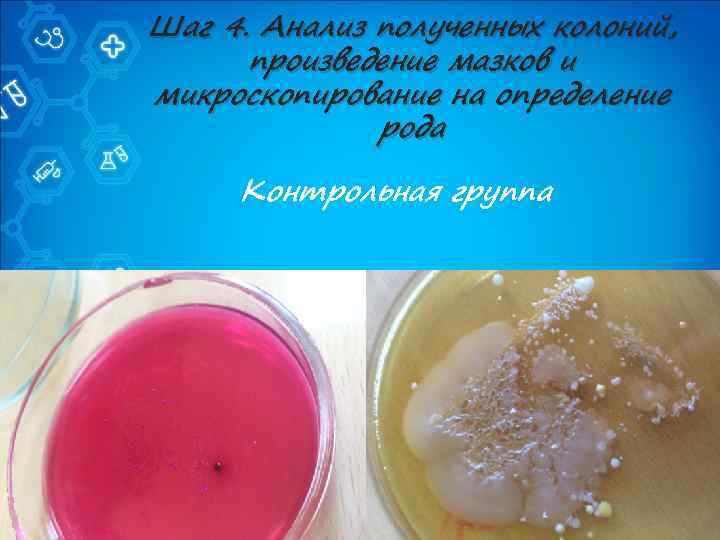
Шаг 4. Анализ полученных колоний, произведение мазков и микроскопирование на определение рода Контрольная группа

NonSTop - Анастасия Зотова.pptx
- Количество слайдов: 21
 КОМАНДА «NONSTOP» Г. ВОРОНЕЖ ЗОТОВА АНАСТАСИЯ ЗАДАЧА № 6 ЧТО УПАЛО – ТО ПРОПАЛО
КОМАНДА «NONSTOP» Г. ВОРОНЕЖ ЗОТОВА АНАСТАСИЯ ЗАДАЧА № 6 ЧТО УПАЛО – ТО ПРОПАЛО
 Условие задачи Существует мнение, что если что-то съедобное уронить на пол и поднять меньше чем через 30 секунд, то его все еще можно есть. Рассчитайте скорость перемещения бактерий с одной поверхности на другую. Поставьте эксперимент.
Условие задачи Существует мнение, что если что-то съедобное уронить на пол и поднять меньше чем через 30 секунд, то его все еще можно есть. Рассчитайте скорость перемещения бактерий с одной поверхности на другую. Поставьте эксперимент.
 Цель В ходе эксперимента выявить, можно ли употреблять пищу, которая подверглась сильному загрязнению.
Цель В ходе эксперимента выявить, можно ли употреблять пищу, которая подверглась сильному загрязнению.
 Задачи 1) Сделать посевы с загрязненного продукта питания и одноименного свежего 2) Произвести микробиологические мазки на определение полученных культур 3) Сравнить полученные результаты 4) Сделать вывод о степени риска употребления 5) Оценить возможность расчета скорости передвижения микроорганизмов с поверхности на поверхность
Задачи 1) Сделать посевы с загрязненного продукта питания и одноименного свежего 2) Произвести микробиологические мазки на определение полученных культур 3) Сравнить полученные результаты 4) Сделать вывод о степени риска употребления 5) Оценить возможность расчета скорости передвижения микроорганизмов с поверхности на поверхность
 Для установления достоверности гипотезы « 30 секунд» был поставлен эксперимент. Условия проведения опыта были максимально приближены к естественным.
Для установления достоверности гипотезы « 30 секунд» был поставлен эксперимент. Условия проведения опыта были максимально приближены к естественным.
 Постановка эксперимента Шаг 1. Покупка опытного образца
Постановка эксперимента Шаг 1. Покупка опытного образца
 Постановка эксперимента Шаг 2. Произведение посева на питательные среды Эндо и МПА
Постановка эксперимента Шаг 2. Произведение посева на питательные среды Эндо и МПА
 Контрольная группа
Контрольная группа
 Опытная группа
Опытная группа
 Шаг 3. Посевы хранились в термостате при t=37◦C 2 суток
Шаг 3. Посевы хранились в термостате при t=37◦C 2 суток
Шаг 4. Анализ полученных колоний, произведение мазков и микроскопирование на определение рода Контрольная группа
Шаг 4. Анализ полученных колоний, произведение мазков и микроскопирование на определение рода Контрольная группа
 Опытная группа
Опытная группа
 Шаг 5. Произведение окраски по Граму
Шаг 5. Произведение окраски по Граму
 Шаг 6. Определение родовой принадлежности
Шаг 6. Определение родовой принадлежности
 На контрольном и опытном образцах на среде Эндо обнаружены: 1) Хаотично расположенные Гркороткие тонкие палочки с закругленными концами и жгутиками Это свидетельствует о присутствии рода Escherichia. 2) Различие между контрольным и опытным образцом состоит в разном числе колоний
На контрольном и опытном образцах на среде Эндо обнаружены: 1) Хаотично расположенные Гркороткие тонкие палочки с закругленными концами и жгутиками Это свидетельствует о присутствии рода Escherichia. 2) Различие между контрольным и опытным образцом состоит в разном числе колоний
 На контрольном и опытном образцах на среде Эндо обнаружены: 1) Расположенные гроздьями Гр+ шаровидные неподвижные клетки. Это предположительно говорит о присутствии рода Staphylococcus. 2) Различие между контрольным и опытным образцом состоит в разном числе колоний 3) В опытном образце найдены расположенные цепочками Гр+ шаровидные неподвижные клетки. Это предположительно говорит о присутствии рода Streptococcus.
На контрольном и опытном образцах на среде Эндо обнаружены: 1) Расположенные гроздьями Гр+ шаровидные неподвижные клетки. Это предположительно говорит о присутствии рода Staphylococcus. 2) Различие между контрольным и опытным образцом состоит в разном числе колоний 3) В опытном образце найдены расположенные цепочками Гр+ шаровидные неподвижные клетки. Это предположительно говорит о присутствии рода Streptococcus.
 Путешествие по поверхностям Отвечая на вопрос задачи о скорости передвижения бактерий с поверхности на поверхность, можно сказать, что : 1) У родов Streptococcus и Staphylococcus она равна 0 2) У рода Escherichia она варьирует от 0 до скорости активности переносчика бактерии.
Путешествие по поверхностям Отвечая на вопрос задачи о скорости передвижения бактерий с поверхности на поверхность, можно сказать, что : 1) У родов Streptococcus и Staphylococcus она равна 0 2) У рода Escherichia она варьирует от 0 до скорости активности переносчика бактерии.
 Патогенны ли? Судить о степени патогенности вида мы можем только после проведения лабораторных тестов!!! 1) 2) 3) Наиболее патогенны для человека гемолитические S. pyogenes. Этот вид вызывает у человека многие болезни: скарлатину, ангину, острый эндокардит, послеродовой сепсис, хронический тонзиллит, ревматизм. У стафилококков около 120 клинических форм проявления, которые имеют местный, системный или генерализованный характер. К ним относятся гнойно-воспалительные болезни кожи и мягких тканей (фурункулы, абсцессы), поражения глаз, уха, носоглотки, уро-генитального тракта, пищеварительной системы (интоксикации). При эшерихиозе болезнь начинается остро, с повышения температуры тела, болей в животе, поноса, рвоты. Отмечаются нарушение сна и аппетита, головная боль.
Патогенны ли? Судить о степени патогенности вида мы можем только после проведения лабораторных тестов!!! 1) 2) 3) Наиболее патогенны для человека гемолитические S. pyogenes. Этот вид вызывает у человека многие болезни: скарлатину, ангину, острый эндокардит, послеродовой сепсис, хронический тонзиллит, ревматизм. У стафилококков около 120 клинических форм проявления, которые имеют местный, системный или генерализованный характер. К ним относятся гнойно-воспалительные болезни кожи и мягких тканей (фурункулы, абсцессы), поражения глаз, уха, носоглотки, уро-генитального тракта, пищеварительной системы (интоксикации). При эшерихиозе болезнь начинается остро, с повышения температуры тела, болей в животе, поноса, рвоты. Отмечаются нарушение сна и аппетита, головная боль.
 Путешествие по поверхностям Отвечая на вопрос задачи о скорости передвижения бактерий с поверхности на поверхность, можно сказать, что : 1) У родов Streptococcus и Staphylococcus она равна 0 из-за отсутствия жгутиков 2) У рода Escherichia она варьирует от 0 до скорости активности переносчика бактерии, впрочем, как и у 2 х вышеперечисленных родов.
Путешествие по поверхностям Отвечая на вопрос задачи о скорости передвижения бактерий с поверхности на поверхность, можно сказать, что : 1) У родов Streptococcus и Staphylococcus она равна 0 из-за отсутствия жгутиков 2) У рода Escherichia она варьирует от 0 до скорости активности переносчика бактерии, впрочем, как и у 2 х вышеперечисленных родов.
 Вывод: Таким образом, поднятие еды с пола и ее употребление сравнимо с русской рулеткой. Все зависит от того, какой микроорганизм попал на пищу, и насколько силен иммунитет гурмана.
Вывод: Таким образом, поднятие еды с пола и ее употребление сравнимо с русской рулеткой. Все зависит от того, какой микроорганизм попал на пищу, и насколько силен иммунитет гурмана.
 Спасибо за внимание
Спасибо за внимание


